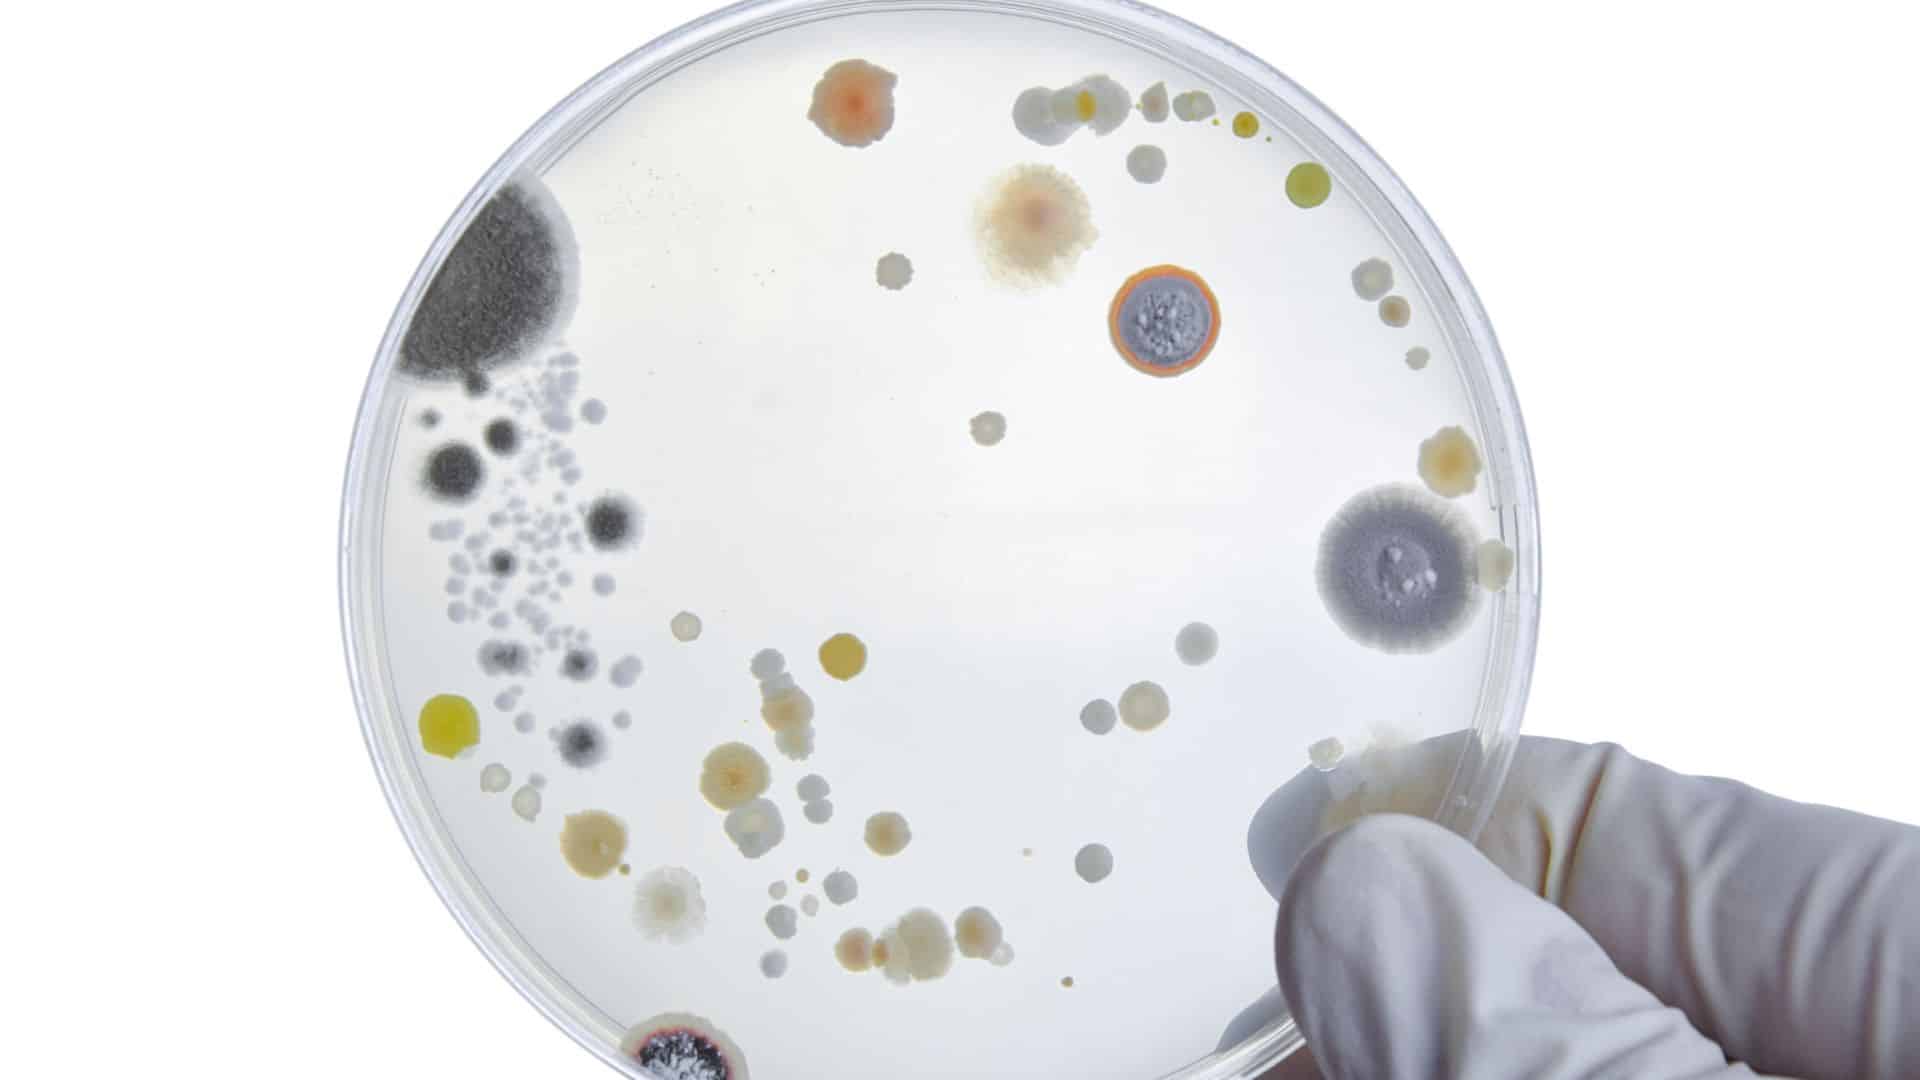
Bacteria on a petri dish

USDA Recalls 13,720 Pounds of Ready-to-Eat Chicken Over Listeria Contamination


Suzanna’s Kitchen, a Norcross, Georgia establishment, is recalling approximately 13,720 pounds of ready-to-eat grilled chicken breast fillet products that may be contaminated with Listeria monocytogenes, the U.S. Department of Agriculture’s Food Safety and Inspection Service announced January 16, 2026. The chicken was produced on October 14, 2025, and shipped to foodservice distribution centers across seven states.
The problem surfaced when a third-party laboratory sample tested positive for Listeria monocytogenes in the ready-to-eat, fully cooked grilled chicken breast fillets product. The recall applies to 10-pound cases containing two 5-pound bags of fully cooked grilled chicken breast fillets with rib meat. Foodservice operators have been urged to check their inventories immediately for any matching products.
There have been no confirmed reports of illness due to consumption of these products. The affected chicken was distributed to foodservice sales centers in Alabama, Florida, Georgia, Missouri, New Hampshire, North Carolina, and Ohio. Some of the products could still be in commercial refrigerators or freezers at restaurants and foodservice facilities, making it important for operators to verify what’s currently on hand.
How to Identify the Recalled Chicken Products

The recalled chicken can be identified by lot code 60104 P1382 287 5 J14, which appears on both the side of the case and on individual packages. This code marks chicken produced on October 14, 2025, at Suzanna’s Kitchen’s facility, allowing foodservice operators to identify exactly which inventory needs removal. The establishment number P-1382 also appears inside the USDA mark of inspection on the case label, providing a secondary verification method for concerned businesses.
Foodservice sales centers have been urged to check their inventories immediately and remove any matching products. The recall targets distribution centers rather than retail grocery stores, meaning the product was intended for restaurants, cafeterias, and other commercial food preparation facilities. Anyone with questions regarding the recall can contact Dawn Duncan, Customer Service Director at Suzanna’s Kitchen, at [email protected], while media inquiries should be directed to Craig Pate, Chief Financial Officer, at [email protected].
Consumers with food safety questions can call the toll-free USDA Meat and Poultry Hotline at 888-674-6854 or send questions via email to [email protected]. For those who need to report a problem with a meat, poultry, or egg product, FSIS maintains an Electronic Consumer Complaint Monitoring System accessible 24 hours a day at https://foodcomplaint.fsis.usda.gov/eCCF/. Anyone concerned about an illness should contact a healthcare provider immediately.
Understanding the Health Risks of Listeria Contamination
Listeria monocytogenes is especially dangerous for newborns, pregnant women, and elderly adults with weakened immune systems, according to the Centers for Disease Control and Prevention. The bacteria can be found in soil, water, sewage, and on animals, according to the U.S. Food and Drug Administration. It survives in contaminated products even when refrigerated, and transmission occurs when food is prepared or stored in contaminated conditions, the FDA stated.
The CDC estimates that 1,250 people contract listeria infections each year in the United States, and 172 people die from the bacteria annually. Symptoms of listeria exposure can develop anywhere from three to 70 days after eating contaminated food, according to the CDC. The extended timeframe creates a wide window during which people may not connect their illness to a specific product. Symptoms range from fever and nausea to more serious cases involving headaches, loss of balance, and convulsions, the CDC stated.
Even healthy people can get sick from listeria contamination, with symptoms that may include fever, headache, nausea, abdominal pain, and diarrhea. The extended incubation period makes tracking outbreaks challenging, as people who consumed contaminated products weeks earlier may not realize the connection to their illness. Anyone who thinks they may have been exposed and feels unwell should contact a healthcare provider, particularly those who fall into one of the high-risk categories identified by the CDC.
Suzanna’s Kitchen Previously Recalled Chicken Products in December

In December 2025, Suzanna’s Kitchen issued a recall of approximately 62,550 pounds of fully cooked, bone-in breaded chicken products. That recall stemmed from misbranding and an undeclared allergen, with soy not listed on the label of 18-pound cases of eight-piece cut, bone-in breaded chicken portions. The recalled chicken had been shipped to restaurants nationwide, and no illnesses were reported in connection with that product.
FSIS expressed concerns during the December recall that restaurants might still have the product in freezers and urged businesses to discard the chicken immediately. Both recalls involved products distributed through foodservice channels rather than retail stores, highlighting the challenge of tracking items once they enter commercial food operations. Foodservice products can remain in commercial storage for extended periods before use, unlike retail items purchased directly by consumers.
Both recalls were voluntary actions by the Georgia-based company. Suzanna’s Kitchen did not immediately respond to media requests for comment regarding the listeria contamination, according to The Independent. Foodservice operators who have purchased products from Suzanna’s Kitchen should check lot codes and establishment numbers on all inventory, particularly items stored since October or earlier.
